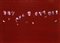

33° ASTA | arte moderna e contemporanea - Main Section SECONDA SESSIONE | LOTTI 69-186
martedì 31 ottobre 2023 ore 16:00 (UTC +01:00)
PUGLISI Lorenzo, Il grande sacrificio 4
Lorenzo PUGLISI, Il grande sacrificio 4, 2021, olio su cartoncino applicato su tavola, cm 50x70
Titolo, data, firma "Il grande sacrificio 4, 2021, Puglisi" (al retro)